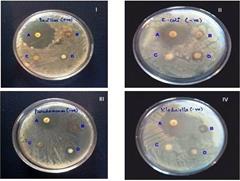
9

Department of Biochemistry and Biotechnology, Faculty of Science, Annamalai University, Annamalainagar 608002, Tamilnadu, India
Email: sivaseenu77@gmail.com
Received: 20 Jan 2016 Revised and Accepted: 20 Apr 2016
ABSTRACT
Objective:This study aims to investigate the green synthesis of silver nanoparticles (AgNPs) Melothria maderaspatana (MM), and evaluation of their antibacterial activities for the first time. It is observed that MM leaf extract can reduce silver ions into AgNPs.
Methods: The obtained particles were analyzed by UV-visible spectrophotometry, scanning electron microscopy (SEM), Fourier transform infrared (FT-IR) spectroscopy, to understand the morphology of AgNPs. In addition, the antibacterial activity by MM extract synthesized AgNPs (MM AgNPs) was also investigated. FTIR spectroscopic studies were carried out to find possible bio-reducing agent present in the plant leaves.
Results: The formation and stability of the reduced AgNPs in the colloidal solution were monitored by UV-Vis spectrophotometer analysis. SEM and FT-IR spectra of the leaf extract after the development of nanoparticles are determined to allow identification of possible functional groups responsible for the conversion of metal ions to metal nanoparticles.
Conclusion: Further, the AgNPs thus acquired showed highly potent antibacterial activity toward Gram-positive (Bacillus cereus) and Gram-negative (E. coli, pseudomonas aeruginosa, and Klebsiella sps) microorganisms.
Keywords: Green synthesis, Nanoparticles, Melothria maderaspatana, Antibacterial activity, Human pathogens
© 2016 The Authors. Published by Innovare Academic Sciences Pvt Ltd. This is an open access article under the CC BY license (http://creativecommons.org/licenses/by/4.0/)
INTRODUCTION
Noble metal nanoparticles are gaining lot of implication for the past few years due to their applicability in the field of medicine, biology, material science, physics and chemistry [1]. The early phase of these technology fusions both physical and chemical methods for the synthesis of nanomaterials using toxic chemicals and harsh reaction conditions [2, 3]. These nanostructures have the tendency to release harmful byproducts into the environment leading to toxicological issues. To overwhelmed this, there is a need for clean, non-toxic, bio-compatible and environment-friendly materials synthesized via ‘green’ approach [4]. Such characteristics have nanoparticles currently playing significant roles in medical diagnostics, drug delivery systems, antisense and gene therapy applications and tissue engineering. Among the several noble metal nanoparticles, silver metal nanoparticles have attained special focus in view of their distinctive properties, like good electrical conductivity, chemical stability, catalytic, bacterial activity [5], integrated circuits, sensors, biolabelling, filters, biomedical devices [6], clothing [7], food industry [8], sunscreens and cosmetics [9,10]. Moreover, at low concentration silver compounds are non-toxic to the human body compared to other noble metals [11].
Like nano-organisms viruses, nanoparticles are able to enter cells and interact with subcellular structures. Cellular uptake, subcellular localization, and ability to catalyze oxidative products depend on nanoparticle chemistry, size and shape [12]. The mechanism by which nanoparticles penetrate cells without specific receptors on their outer surface is assumed to be a passive uptake or adhesive interaction [13]. This uptake may be initiated by van der Waals forces, electrostatic charges, steric interactions, or interfacial tension effects and does not result in the formation of vesicles. The plant world has been revisited with the renewed interest since the perception of nature's ability to work as a nano factory. The advantages of using plant and plant-derived materials for biosynthesis of metal nanoparticles have interested researchers to investigate mechanisms of metal ion uptake and bioreduction by plants, and to understand the possible mechanism of metal nanoparticle formation [14]. However, the potential of plants as biological materials for the synthesis of nanoparticles is yet to be fully explored. Moreover, the exact mechanism of silver nanoparticles (AgNPs) synthesis by plant extracts is not yet fully understood although the participation of phenolics, proteins and reducing agents has been speculated. Hence, there is still a need for an economical, the commercially viable as well as environmentally clean route to synthesize nanoparticles that can be safely applicable for human use.
The present study attempts to fill the knowledge gap by investigating the synthesis, stability and antimicrobial ability of AgNPs synthesized by Melothria maderaspatana (MM) leaf extract. MM (family: Cucurbitaceae) is an annual monoecious plant having scandent or prostrate stems, very hispid, leaves are variable in size, densely covered with white hairs. It is found throughout India ascending up to 1800 m in the hills. The tender shoots and bitter leaves are used as a gentle aperient and prescribed in vertigo and biliousness [15]. This plant has a unique place in the Siddha system of medicine. MM has been shown to exert hepatoprotective, antioxidant, anti-inflammatory, antiarthritic activities [16], immunomodulatory activity [17], antimicrobial activity [18], hypolipidemic [19], jaundice [20] and use to treat diabetes mellitus [21]. AgNPs have a high specific area which will lead to excellent antimicrobial activity.
Hence, the present study was aimed to synthesize AgNPs rapidly using aqueous leaves extract of MM plant, to investigate the biomolecules responsible for the synthesis of AgNPs. To the best of our knowledge, the use of MM leaf extract for the green synthesis of noble nanoparticles, such as AgNPs has not been reported so far. The obtained particles were analyzed by UV-visible spectrophotometry, scanning electron microscopy (SEM), Fourier transform infrared (FT-IR) spectroscopy, to understand the morphology of AgNPs. The physical, chemical and biological activity of the choosen compound is studied in detail experimentally for future pharmaceutical applications.
MATERIALS AND METHODS
All chemicals used in the present study are of high pureness and are procure from Sigma (Bangalore, India). MM (Voucher specimen: AECBT-09/2011) were collected from in and around Parangipettai, Chidambaram, Tamilnadu, India.
Preparation of plant extract
Plant leaves were collected and sterilized the surface thoroughly with distilled water and shade dried for 10 d, grounded into a fine powder using a kitchen blender. For the production of AgNPs, 20 g leaf powder was taken and mixed with 200 ml of distilled water and kept in boiling water bath at 60 °C for 10 min. The extracts were filtered with Whatman filter paper No.1 after cooling and stored in a refrigerator at 4 °C for further studies.
Synthesis of AgNPs
Silver nitrate (AgNO3) was obtained from Sigma chemical Co. (st. Louis, Mo. USA). For the synthesis of AgNPs, 1 mM aqueous solution of AgNO3 was used. The reaction mixtures was prepared by adding 10 ml of the plant crude extracts to 90 ml of 1 mM AgNO3 solution in a 250 ml Erlenmeyer flask and its kept boiling water bath for 10 min and then filter it with Whatman filter paper No.1 kept in various temperature such as 37 °C, 50 °C, 60 °C to 100 °C. By the spectrophotometrically the reaction mixture was monitored at every 10 min interval from 0 to 60 min. Reduction of AgNPs was detected by a change in their colour of the reaction mixture during temperature treatment [22].
Characterization of AgNPs
Amalgamated AgNPs were initially characterized by sampling small aliquot of sample into UV-visible spectrophotometer absorption spectra at 300-700 nm using SHIMADZU spectrophotometer. For additional characterization, by repeated centrifugation at 5000 rpm for 5 min to synthesize purified AgNPs. The resultant pellet was resuspended in Milli-Q water and freeze-dried, from this thin film, was prepared for SEM (JEOL-ISM-5610LV with INCA EDS) analysis.
FTIR analysis
FTIR spectroscopic studies were carried out to the invention of possible bio-reducing agents were present in the plant leaves. The wavelength spectrum of the leaf extracts before and after the addition of AgNO3, the samples were mixed with KBr powder and pelletized after drying the spectra were recorded using Perkin Elmer make model spectrum RX1 (wavelength range between 4000 cm−1 and 400 cm−1)
Screening of antimicrobial activity
The antimicrobial effect was evaluated against human pathogens such as Gram positive (Bacillus cereus) and Gram negative (E. coli, pseudomonas aeruginosa, Klebsiella sps) by synthesized MMAgNPs and crude plant extract by the disc diffusion method [23]. These pathogens were obtained from Department of Microbiology, Annamalai University. Cultures were maintained at 80 °C on glycerol stock. Clinically isolated strains were subcultured in nutrient broth for 24 h at 30 °C. Each strain was swabbed uniformly into the individual nutrient agar plates using sterile cotton swabs. Using sterile micropipette, 50 µl of MM, Melothria maderaspatana silver nanoparticles (MM AgNPs) and purified AgNPs were loaded onto a sterile paper disc and it was allowed to dry. The sample loaded discs along with standard antibiotic disc (tetracycline) were infused in the nutrient agar medium. After 24 h incubation at 37 °C, the different levels of the zone of inhibition were dignified.
RESULTS
Visual examination
The diluted leaf extract had a pale yellow colour and appeared turbid soon after adding AgNO3. After the solution was kept in sunlight, the concentration of the colour improved gradually from pale yellow to dark brown at the end of the experiment. The colour change in the solution is presented in fig.1. Expectedly, under the same experimental conditions, control samples showed no change in colour.
UV-visible spectrum analysis
Optical measurement is the prime technique for characterizing the biological synthesis of nanoparticles. Fig. 2 displays the UV-visible spectra of the samples periodically withdrawn and exposed to UV-visible spectroscopy during the experiment. A broad peak located at 420 nm was observed after 5 min of exposure in sunlight. The height of the peak, i.e. the absorbance, increased with time till the end of the experiment. However, a gradual shift in the peak from 420 to 400 nm characteristic of surface plasmon resonance of AgNPs formation is observed that remained constant till the end of the experiment.
SEM analysis
The SEM micrograph provided further information about the morphological characteristics of the particles synthesized. It was confirmed that the particles were spherical in shape. The scanning electron micrograph of the nanoparticles at 28-31 nm is shown in the fig. 3.

Fig. 1: Insets photographs showing colour variations after different reaction time intervals

Fig. 2: UV-vis spectra recorded as a function of the reaction time for the reaction of 1 mM AgNO3 solution with MM

Fig. 3: FE-SEM image of AgNPs that were synthesized by leaf extract of MM A and B
FTIR analysis

A

B
Fig. 4: The merge FTIR spectra of the leaf extract of MM (A) and MM AgNPs (B)
The FTIR spectrum analysis of MM AgNPs and the plant extract difference in transmittance and modification stretches at 3423.95 cm−1, 2922.30 cm−1, 2649.30 cm−1, 1629.59 cm−1, 1382.55 cm−1 and 1108.23 cm−1 in MM plant extract 3394 cm−1, 2078 cm−1, 1408 cm−1, 1025 cm−1, 1638 cm−1 and 672 cm−1 is revealed in fig. 4.
Antibacterial test
The synthesized AgNPs showed antibacterial activity against the tested microorganisms which was confirmed by the formation of inhibition zones of various diameters as shown in fig.5.
The result of the antibacterial test (diameters of zone of inhibition) is tabulated in Table1. It was perceived that the AgNPs were most effective against pseudomonas Aeruginosa followed by Bacillus cereus, E. coli and Klebsiella sps. The control sample containing only plant extract did not show antibacterial activity against any of the tested microorganisms.
Fig. 5: Bactericidal effects (A) standard antibiotic drug, (B) purified AgNPs, (C) plant extract and (D) MM AgNPs. Tetracycline was used as standard drug
Table 1: Zone of inhibition observed with different bacterial strain culture plates loaded with MM AgNPs and antibiotics
Human pathogenic bacteria |
Zone of inhibition in mm |
Plant extract |
AgNO3 |
MM AgNPs |
Standard antibiotic disc (tetracycline) |
||||
Bacillus cereus |
28 |
8 |
3 |
12 |
Escherichia coli |
19 |
5 |
3 |
10 |
Pseudomonas aeruginosa |
19 |
6 |
4 |
13 |
Klebsiella sps |
15 |
4 |
2 |
13 |
DISCUSSION
Green synthesis of AgNPs
Current research on the green synthesis of nanomaterials using plant extracts has opened a new era. The present study deals with the synthesis of AgNPs using aqueous leaf extracts of MM. Temperature dependent approach was implemented to make nanoparticles by reducing AgNO3 solution. It has been observed that the increase in temperature results in the rapid biosynthesis of nanoparticles. At this junction, the conversion rate of silver ions to AgNPs at 90 °C. This is further confirmed by the formation dark brown color (fig.1) in the colloidal solution due to excitation of surface plasmon vibrations. In 1 mM AgNO3 (control) solution there is no colour change observed (fig.1).
By the temperature and incubation, in this study, leaf extract shows improved synthesis of AgNPs at 90 °C when compared to below 90 °C, significantly influencing the synthesis process of AgNPs.Usually, the synthesis of nanoparticle increases with increase in temperature and incubation period [24]. The Changes of colour from yellowish to brown due to the reduction process of silver ions when the leaf extract was mixed with aqueous solution of AgNo3 [25]. The synthesized AgNPs were confirmed based on the UV-visible spectra at 420 nm due to the excitation of SPR [26].
Characterization of AgNPs
UV-visible absorbance spectroscopy is a useful technique especially to characterize noble metal nanoparticles [27] because they possess bright colour visible by naked eye. Colloidal solutions of AgNPs show a very intense colour. It is an indication of AgNPs formation as the colour change observed is due to the excitation of surface plasmon vibrations in AgNPs [28]. These nanoparticles possess high extinction coefficient and their surface plasmon property is the size and shape dependent. The surface plasmon resonance shows a yellowish brown-shift in the extrinsic size region and as the particle size increases [29]. When the interparticle distances of nanoparticles become less that their average diameter the particles aggregate so that the plasmon resonances of each particle couple and their absorbance is brown shifted. Surface Plasmon peak observed confirms the influence of aqueous MM leaf extract in reducing silver ions to AgNPs from aqueous AgNO3 solution. The broad surface plasmon resonance band perceived about 400 to 420 nm (fig. 2) indicates that the particles are large and polydispersed [28, 30].
Morphological and topography studies were explored using Field Emission Scanning Electron Microscopy (FE-SEM) it can go up to 1,00,000 magnification with a resolution of ∼1.5 nm [31]. It was observed that they were spherical in shape with a smooth surface (fig 3). The shape of the particles has correlated with SPR band at 420 nm for AgNPs. FE-SEM imageries of produced nanoparticles using MM Linn leaf extract was establish to be spherical in shape. The size of AgNPs was found to be 28-31 nm. The resulting AgNPs were mostly constant in size. Although the exact shape of the nanoparticles was clearly predicted.
The particle shape of plant-mediated AgNPs was mostly spherical with an exception of neem (Azaddirachita indica) which yielded polydisperse particles both with a spherical and flat plate-like morphology 5-35 nm in size [32]. SEM images of AgNPs from Emblica officinalis were also predominantly spherical with an average size of 16.8 nm ranging from 7.5 to 25 nm [33]. This obtained product correlated with a previous report obtained using papaya fruit extract which was at a range of 25 to 50 nm [34].
To understanding the involvement of functional groups in the relation between metal particles and biomolecules, FTIR places first, and it is an important tool. Functional groups attached to the metal nanoparticle surface show different FTIR pattern than those of free groups [35]. Hence, FTIR gives information about the surface chemistry of nanomaterials. FTIR measurements were performed to identify the possible biomolecules responsible for capping and stabilizing the AgNPs. FTIR measurements of synthesized dried AgNPs were carried out to identify the possible biomolecules responsible for the reduction of the Ag+ ions and capping of the bio-reduced AgNPs synthesized by the leaf extract. In the present study, a medicinal plant was evaluated for the synthesis of AgNPs in short reaction time. MM has been known to hold an appreciable amount of tannin, alkaloids triterpenes, glycosides, protein, carbohydrate, steroids and flavonoids which may be possibly supportive in the synthesis of nanoscale value particles. Fig. 4 shows the FTIR spectrum analysis of plant extract and the MM AgNPs variation in transmittance and modification stretches at 3423.95 cm−1, 2922.30 cm−1, 2649.30 cm−1, 1629.59 cm−1, 1382.55 cm−1 and 1108.23 cm−1 in MM plant extract 3394 cm−1, 2078 cm−1, 1408 cm−1, 1025 cm−1, 1638 cm−1 and 672 cm−1 may be due to the interaction of biomolecules with silver nanoscale particles, the outcomes of results depicts the occurrence of phytoconstituents such as flavonoids, tannin, triterpenes present in the leaf extract which may be possibly influence the reduction and stabilization of silver nanoscale particles [36].
Antimicrobial activity of MM AgNPs
Silver is well known as one of universal antimicrobial substances. Biosynthesized AgNPs were analyzed for their antimicrobial activity against E. coli, pseudomonas Aeruginosa, Klebsiella sps and Bacillus cereus by disk diffusion method (fig. 5). It was observed that microbial growth was independent on AgNP concentration. The phytoconstituents like triterpenes, flavonoids, and alkaloids may be responsible for the antimicrobial activity. It presents in the leaf extracts of MM. Since the AgNPs antimicrobial activity has not been reported, an attempt has been made to find the antimicrobial activity of leaf extracts of MM on bacteria. Gram-positive bacteria (Bacillus cereus) and Gram negative (E. coli, pseudomonas Aeruginosa, Klebsiella sps) were used for the study. Exact antimicrobial effect of AgNPs was still unclear, suggesting three different possible mechanisms of action, involving first silver ions attach to the bacterial cell membrane and cause plasmolysis (cytoplasm of bacteria separated from bacterial cell wall), inhibit the bacterial cell membrane synthesis [37]. Secondly, AgNPs could strongly interact with sulphur-phosphorus containing compounds present inside (DNA, proteins) and outside (membrane proteins) of a bacterial cell, affecting respiratory chain reaction, cell division and finally leads to cell death [38]. Finally, AgNPs release silver ions that will penetrate into the cell wall causing condensation of DNA damage and also by affecting the protein synthesis [39]. Overall results showed the involvement of all the three phenomena of synthesized particles leading to the damage to pathogens or killing the pathogens. AgNPs pretense of having bactericidal strong activity against gramnegative and grampositive bacteria. In the present study, the AgNPs showed more than 10 mm zone of inhibition in all four species (table 1). Comparatively, tetracycline was used as a positive control. It is clear from the study, AgNPs by green synthesis can compete antimicrobial commercial agents (antibiotics) used for the treatment of bacterial infections.
CONCLUSION
In this striving, traditional herbal medicines must perforce be granted the benefits of modern science and technology to serve further global needs. We have developed a fast, eco-friendly, and convenient green method for the synthesis of AgNPs from AgNO3 using MM leaf extract at ambient temperature. Spherical, polydisperse AgNPs of particle sizes ranging from 28 to 31 nm with an average size are obtained. Colour changes occur due to surface plasmon resonance during the reaction with the ingredients present in the MM extract resulting in the formation of AgNPs, which is confirmed by FTIR, UV-Vis spectroscopy, and SEM. FTIR spectroscopic study confirmed that the carbonyl group of amino acid residues has a strong binding ability with silver, suggesting the formation of a layer covering AgNPs and acting as a capping agent to prevent agglomeration and provide stability to the medium, yet further research is needed in this area to explore the possible biomolecule responsible for the bioreduction process. The antibacterial activity of AgNPs shows much potent inhibitory activity against clinically isolated pathogens. The drugs derived from herbs may have the possibility of their use in medicine because of their good antibacterial activity.
CONFLICT OF INTERESTS
Declared none
REFERENCES